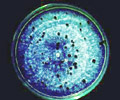

白絹病
灰黴病
疫病
根腐病
病毒病
細菌性軟腐病
貯藏病害
葉蚜線蟲
栽培時期非傳染性病害
萎凋病
百合斑紋病毒
百合隱徵型病毒
胡瓜嵌紋病毒 |
灰黴病 (Gray
mold)
病原菌:Botrytis
elliptica (Berk.) Cooke 一般灰黴病係指由
Botrytis cinerea Pers. 感染所引起者。B. cinerea
為一多犯性病菌,寄主範圍寬廣,偏好低溫高濕環境,我國冬季裡作至翌年梅雨前後為本病害主要發生時期,環境合適下常嚴重發病,造成花卉業重大損失。B.
cinerea 亦能感染百合,但由文獻記載及實際分離鑑定結果,百合灰黴病主要由另一病原 B.
elliptica (Berk.) Cooke 感染所引起。兩病原間除孢子形態有所差異外,B.
elliptica
的寄主範圍較為窄狹,除百合屬植物外未見其它寄主之報導。灰黴病菌感染百合葉片及花器時,會造成葉片焦枯、花苞畸形及後期花瓣萎凋,嚴重影響百合切花品質及種球的培育。
病徵:
灰黴病菌能感染百合葉片、莖及花器,葉片病徵初期為透明水浸狀小斑點,爾後急速擴大為褐至紅褐色長橢圓形,大小約
0.4-0.6×0.9-1.5cm
之病斑,邊緣呈水浸狀,在低溫潮濕的季節裡病斑表面著生灰至灰褐色之黴狀物,嚴重時多數病斑癒合,造成葉片焦枯。我國露天栽培的百合嚴重發病時,常見整畦若火燒狀,足見其為害之烈。病害發生後若遇乾燥或高溫逆境,病勢則被抑止形成靜止型病斑,病斑邊緣下陷,中間部位乾枯,形成易脆裂的壞死組織。Doss
(1988) 曾報導 B. elliptica
感染鐵炮百合葉片時亦能形成明顯黃色條斑。病菌感染花瓣初期產生針尖狀退色斑,病斑擴大後轉成淺褐色,感染輕微時僅引起花器畸形,嚴重發生時則整朵花凋萎,環境潮濕下萎凋的花朵上可見滿佈灰褐色之黴狀物,為病菌之分生孢子。
病原菌:
|
分 類: |
Deuteromycotina (不完全菌亞門)
Hyphomycetes (絲孢綱)
Moniliales (叢梗孢目)
Moniliaceae (叢梗孢科)
Botrytis (葡萄孢屬) |
|
分 佈: |
由 B. elliptica
所引起之灰黴病適合於低溫高濕環境下發生,一般百合生產區均符合此條件,如美國、歐洲、義大利、紐西蘭、日本、韓國及臺灣等皆有發生之記載。 |
|
寄 主: |
B. elliptica 的寄主範圍不若 B. cinerea
之寬廣,就目前所知僅限於百合科植物的 Lilium
一屬,但不同品種間抗感性有明顯的差異,其中鐵炮百合最感病,亞洲型百合如姬百合次之,而東方型百合如香水百合較為抗病,但同為東方型的葵百合則為感病品種。 |
|
形 態: |
葡萄孢屬中的多個種均已有有性世代的記載,如 Botryotinia fuckeliana (Botrytis
cinerea)、Botryotinia draytoni (B. gladiolorum)、Botryotinia
arachidis (B. arachidis)、Botryotinia convoluta (B. convoluta)
等。但迄今 Botrytis elliptica
尚未有有性世代的記載。菌絲於患部產生無性世代分生孢子,甚少形成菌核。分生孢子梗直立呈暗褐色,長約 500μm,頂端具
2-4
分枝,其上著生分生孢子。分生孢子無色,長橢圓形,底端微尖,大小約16-34×10-24μm,聚集在孢子梗頂端,形成大小為
75-85μm 之孢子團。Botrytis elliptica
在馬鈴薯葡萄糖培養基上生長兩週即可產生菌核,菌核黑色不整形,大小為
2.6-14.7×1.8-5.9μm。將田間百合病葉置於 20℃ 定溫濕室內,約 15
天後亦可形成黑色菌核,但較培養基上所形成者小,約為 0.4-3.44×2.7-1.06μm。 |
|
診斷技術: |
百合灰黴病的患部可在潮濕的環境下產生大量灰色黴狀物,或為其典型之病兆
(sign),若田間觀察到典型病兆時,即能正確診斷此病害。但是在一般百合生長的季節裡,此典型病兆並不常見,反而是與炭疽病極類似之葉斑病徵較為普遍,診斷時可以將病葉置於溼室內誘導其產孢,或將病葉經表面消毒後置於馬鈴薯葡萄糖培養基上培養,觀察是否長出白色棉絮狀菌絲,菌絲經兩週之培養後會有漆黑色、不整形之菌核長出即可正確判別。 |
|
生 活
史: |
Coley-Smith (1980) 曾報導灰黴病菌 B. elliptica
能經由百合種球攜帶傳播,病圃及連作田亦可能殘存越冬菌絲或菌核,而成為翌年之初次感染源,在環境適宜時,越冬菌絲或菌核產出無性世代分生孢子成為感染源,分生孢子可經氣流傳播或雨滴飛濺而接觸寄主葉片或花瓣,發芽後以侵入釘直接穿透角質層侵入寄主細胞或經由傷口及氣孔侵入,若遇低溫高濕之環境則病勢發展迅速,可於患部產生分生孢子,成為二次感染源,再誘發大面積的流行。由於尚未發現
B. elliptica 可形成有性世代子囊孢子,因此菌絲及菌核為最可能之越冬感染源。 |
傳播途徑:
病原菌可在土壤及各種植體殘株上存活生長,適當的環境下,在短時間內可形成大量的分生孢子,藉空氣、雨水及外力碰撞作為第二次感染源傳播,亦可藉種球帶菌直接傳播。
發生生態:
百合灰黴病適合於低溫高濕的環境下發生,病菌菌絲生長的適溫為15-25℃而以20℃
為最佳,在 PDA 培養基下,菌核的產生適溫為 10-25℃,而以 15℃ 產生之數量最多。
在含水量 20% 之土壤內,菌核經 20 週後依然可維持 56%
之存活。本病菌分生孢子發芽時水份需求量頗高,游離水或露水之存在有利病菌的侵入及提高罹病率。由田間調查顯示,本病於我國平地百合栽培區由十一月起陸續出現,三至四月的梅雨季發生最嚴重,而高冷地栽培區以六至七月的雨季發生較為嚴重,部份如埔里地區則全年均有發生。
防治方法:
| 一、 |
種植前,必須把殘株收拾乾淨,做好田間衛生工作。並以消毒劑(Methylbromide(溴化甲烷)及Dazomet)處理,一作一次或一年一次視需要情況而定。
(王次男,1991,農藥世界89期,p.88) |
| 二、 |
採用設施栽培,覆蓋遮雨棚,同時避免過於密植,保持通風良好,以減少感病機會。
(楊秀珠,
1991,農藥世界91期,p.71) |
| 三、 |
降低栽培環境中之濕度:供水時避免噴及植株、避免葉面給水、避免於黃昏或清晨大量用水、以稍高溫且低濕度之空氣取代高濕空氣,或於栽培空間灌進乾空氣等,均可降低灰黴病之發生。 |
| 四、 |
加強栽培管理:於植株生長過程中,定期供應鈣肥,可以提高植株對灰黴病之抵抗力,亦不失為一有效之方法。 |
| 五、 |
發病初期一旦發現感病後,應立即清除病株、罹病葉片,可減少病害之傳播。
(楊秀珠,
1995,農藥世界138期,p.39)
|
| 六、 |
藥劑方面目前無推薦藥劑,可參考使用50%撲滅寧可濕性粉劑1500倍、50%免克寧可濕性粉劑1500倍,於易發病之季節噴施。
(謝廷芳、杜金池,興農317期,p.41)
|
|
七、 |
栽培抗病品種:不同百合品種對於灰黴病有抗感性的差異,受季節性溫濕變化之影響,臺灣百合栽培區各有其主要之發病期,在病害流行期勿栽植高感病性品種。 |
|
八、 |
種球消毒:由於種球可能帶菌,因之百合種球栽培前最好予以藥劑消毒。 |
|
九、 |
設施栽培:百合栽培於遮雨棚內能有效降低灰黴病之罹病率,我國簡易塑膠溫室或隧道式遮雨棚極為普及,應盡量行設施栽培。 |
|
十、 |
藥劑防治:嚴重發病期可選用適當藥劑噴灑防治。 |
參考文獻:
| 1.
|
童伯開、陳瑞祥、郭章信、蔡竹固。1998。合灰黴病菌 Botrytis elliptica 的生理特性及殘存。植保會刊
40:371-382。 |
| 2.
|
謝廷芳、杜金池。1993。本省百合灰黴病之發生。植保會刊 35:355 (摘要)。 |
| 3.
|
謝廷芳、黃振文、劉嵋恩。1997。調控設施微氣候防治作物灰黴病。科學農業 45:215-218。 |
| 4.
|
謝廷芳、黃振文。1998。百合灰黴病之發生條件與病勢進展。植保會刊 40:227-240。 |
| 5.
|
Chen, C. Y., and Huang, H. E. 1997. Salicylic acid-induced
resistance of lily leaves against Botrytis elliptica. Plant
Pathol. Bull. 6:76-82. |
| 6.
|
Coley-Smith, J. R., Verhoeff, K., and Jarvis, W. R. 1980.
The biology of Botrytis. Academic Press, New York. 318 pp. |
| 7.
|
Doss, R. P., Chastagner, G. A., and Rilet, K. L. 1984.
Techiques for inoculum production and inoculation of Lily
with Botrytis elliptica. Plant Dis. 68:854-856. |
| 8.
|
Doss, R. P., Chastagner, G. A., and Rilet, K. L. 1986.
Screening ornamental lilies for resistance to Botrytis
elliptica. Scientia Horticulturae 30:237-246. |
| 9.
|
Migheli, Q., Aloi, C., and Gullino, M. L. 1990. Resistance
of Botrytis elliptica to fungicides. Acta Horticulturae
266:429-436. |
|
10. |
Hsieh, T. F., and Huang, J. W. 1999. Effect of film-forming
polymers on control of lily leaf blight caused by Botrytis
elliptica. Europ. J. Plant Pathol. 105(5):501-508. |
| |
|
 |
|
 |
| 葉片上有外圍褐色中間淡色之圓形或橢圓形斑 |
|
多數灰黴病病斑可癒合成大形病斑,嚴重時造成葉枯 |
| (謝廷芳、杜金池,1994,興農317期39頁) |
|
(謝廷芳、杜金池,1994,
興農317期39頁) |
 |
|
|
|
灰黴病菌感染花部所造成之嚴重壞疽病斑 |
|
灰黴病菌於PDA培養基上生長14天後菌落上生出黑色菌核 |
 |
|
|
|
灰黴病菌分生孢子形態 |
|
|
(動植物防疫檢疫局,2000,植物保護圖鑑系列5,第16-21頁)
|